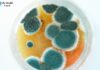
10 Warning Signs of Mold Toxicity: Recognizing the Symptoms 10 Warning Signs of Mold Toxicity: Recognizing the Symptoms

Which Of The Following is Not a Function Of The Respiratory System?
The respiratory system’s primary function is to deliver oxygen to the blood and remove carbon dioxide. The organs of the respiratory system work together to accomplish this task. The nose and mouth are the entry point for air into the body. The trachea, bronchi, and lungs are the primary organs of gas exchange. The diaphragm is a muscle that helps power breathing.
So, based on these functions, we can say that the main function of the respiratory system is to help us breathe. However, there are other functions of this system as well. For example, the respiratory system also helps to regulate our body temperature and humidity levels. Additionally, it plays a role in producing certain sounds, such as speech. So, to answer the question, “Which of the following is not a function of the respiratory system?” we would say that the answer is “helping us see.” The respiratory system does not help us see. Rather, it helps us breathe.
A respiratory system is a group of organs and tissues that work together to help you breathe. The main function of the respiratory system is to take in oxygen and get rid of carbon dioxide. The lungs are the main organs of the respiratory system. The lungs are made up of many tiny air sacs called alveoli. The alveoli are where the exchange of oxygen and carbon dioxide takes place.
The diaphragm is a muscle that helps you breathe. When you breathe in, the diaphragm contracts and moves downward. This makes the chest cavity larger and allows more air to come into the lungs. When you breathe out, the diaphragm relaxes and moves upward.
Which is Not a Function Of The Respiratory System
The respiratory system is responsible for taking in oxygen and expelling carbon dioxide. It does not, however, have a role in digestion or circulation. These functions are performed by other systems in the body. The respiratory system is responsible for taking in oxygen and expelling carbon dioxide. However, there are several other functions of the body that are not related to respiration. Which is Not a Function Of The Respiratory System
For example, the circulatory system transports oxygen-rich blood to the organs and tissues, while the digestive system breaks down food and extracts nutrients. Therefore, while the respiratory system is vital to our survival, it is not the only system that keeps us alive.
The Respiratory System Does Not Assist In
The respiratory system does not assist in the process of digestion. The main function of the respiratory system is to bring oxygen into the body and remove carbon dioxide. This gas exchange occurs in the lungs. The digestive system breaks down food and absorbs nutrients, which are then circulated throughout the body by the bloodstream. While both systems are important for maintaining health, they have different functions.
The respiratory system does not play a direct role in the process of digestion, but it is important for maintaining overall health. The main function of the respiratory system is to bring oxygen into the body and remove carbon dioxide. This gas exchange occurs in the lungs. The digestive system breaks down food and absorbs nutrients, which are then circulated throughout the body by the bloodstream. While both systems are important for maintaining health, they have different functions. Read More: Respiratory Failure ICD 10

You can definitely see your enthusiasm in the work you write. The world hopes for more passionate writers like you who are not afraid to say how they believe. Always go after your heart.